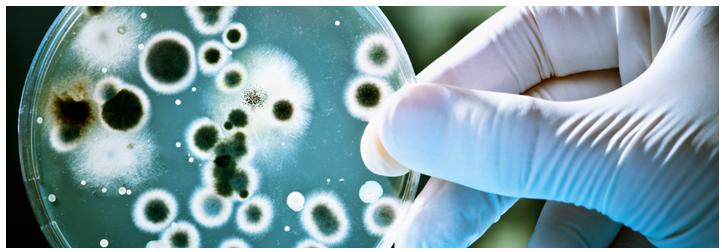

We use cookies to ensure our website works properly and to personalise your experience. Cookies policy

We use cookies to ensure our website works properly and to personalise your experience. Cookies policy
Rathnam Institute of Pharmacy, Pidathapolur, Nellore, India.
Dairy products are highly nutritious and widely consumed globally, but their rich composition also makes them susceptible to microbial spoilage and pathogen contamination. Microbial quality testing is paramount throughout the dairy production chain, from raw milk collection to finished product distribution, to ensure product safety, extend shelf life, and maintain organoleptic properties. Traditional culture-based methods, rapid detection techniques, molecular diagnostics, and advanced analytical methods are all covered in this in-depth examination of the crucial role that microbial quality testing plays in the dairy industry. It discusses the key microbial indicators and pathogens of concern, outlines current regulatory frameworks, and addresses emerging challenges and future perspectives in dairy microbiology. The integration of robust testing protocols with Hazard Analysis and Critical Control Points (HACCP) principles is emphasized as fundamental to safeguarding public health and maintaining consumer confidence in dairy products.
From aged cheese to creamy yogurt, the vast world of dairy products is teeming with microscopic life. These microorganisms, collectively known as microbes, play a crucial role in the production, quality, and safety of dairy products. Some, like those used in fermentation, are beneficial, while others can harm food safety and cause illness or spoilage.
Microbial testing
Microbial Testing in Dairy: Safeguarding Public Health and Product Quality
In livestock farming, antibiotics are frequently used to encourage growth and prevent disease. However, excessive or improper use can leave residues in meat and dairy products, which, when consumed, contribute to the growing global health threat of antibiotic resistance. To counter this, microbial testing serves as a critical safeguard in dairy production, ensuring both safety and quality. It enables producers to detect microorganisms by identifying harmful pathogens such as Salmonella and E. coli, as well as beneficial bacteria that enhance flavor and texture. Through early detection, microbial testing helps prevent foodborne illnesses and protects consumers from serious health risks. By identifying spoilage organisms that can affect taste, texture, and shelf life, it also helps to maintain product quality. Moreover, microbial testing supports the presence of beneficial bacteria like Lactobacillus and Bifidobacterium, ensuring they are maintained at optimal levels to deliver health benefits to consumers.
Common Microbial Testing Methods
Culturable Methods
Molecular Methods
Rapid Methods
Testing methods vary based on product type, target organisms, and required sensitivity.
Key Microorganisms in Dairy
|
Pathogens |
Spoilage Organisms |
Beneficial Bacteria |
|
Salmonella, E. coli, Listeria, Staphylococcus, Campylobacter |
Pseudomonas, Bacillus, Klebsiella, Enterobacteriaceae |
Lactobacillus, Bifidobacterium, Streptococcus thermophilus |
These bacteria can cause diseases ranging from gastroenteritis (E. coli, Salmonella) to pneumonia (Legionella) and food poisoning (Clostridium perfringens).
Food Recalls and Market Impact
Nearly 48% of food recalls stem from microbial contamination. One major incident—the Peanut Corporation of America scandal—led to over 3,200 product recalls, 600 illnesses, and 9 deaths due to Salmonella contamination.
Market Overview
The microbiology testing market is expected to grow at a CAGR of 9.2% from its current value of USD 4.9 billion in 2022 to USD 11.76 billion in 2032. Its applications span healthcare, pharmaceuticals, food and beverage, and environmental monitoring, underscoring its vital role in public health and industry.
Typical Microbiological Standards
Here are some examples of typical microbiological standards for different types of dairy products:

Microbial Standards in Dairy Products
Different dairy types and processing techniques have different microbial limits. Pasteurized milk samples must not contain Salmonella or E. coli and have less than 20,000 bacteria per mL and 10 coliforms per mL. Raw milk allows slightly higher bacterial counts (≤ 30,000/mL) but maintains the same coliform and pathogen standards. Pasteurized cheese must have less than 10 coliforms per gram, whereas unpasteurized cheese can have up to 100 coliforms per gram. There are strict limits on yogurt and dried milk, with dried milk allowing up to 50,000 bacteria per gram and fewer than 10 coliforms per gram. The uniformity and safety of global markets are made possible by these standards.
Importance of Microbial Regulations
Regulations of microbes are necessary for product integrity and public health. By controlling pathogenic bacteria, they reduce the likelihood of foodborne illnesses, extend the shelf life of goods, and promote fair trade by enforcing uniform standards. Additionally, these regulations encourage informed purchasing decisions by fostering consumer confidence in dairy safety and quality.
Mandatory vs Optional Microbial Analyses
Mandatory analyses include:
Optional analyses enhance quality control:
Eurofins: A Leader in Dairy Microbial Testing
Globally, Eurofins offers comprehensive microbial testing services. Pathogen detection by PCR and ELISA, analysis of indicator bacteria, quantification of spoilage organisms, and antibiotic residue screening are among their offerings. Additionally, they use DNA-based milk authentication methods for hygiene audits and environmental monitoring.
Why Choose Eurofins?
Eurofins operates in over 50 countries, offering localized, timely testing. Their accredited labs ensure reliable results, backed by expert teams in food safety. Eurofins supports the dairy industry's regulatory compliance and product excellence with a comprehensive service portfolio and cutting-edge technology.
Eurofins: Safeguarding Dairy Quality
Eurofins plays a pivotal role in ensuring dairy product safety and quality through comprehensive microbial testing. Eurofins contributes to the global delivery of safe, nutritious dairy products by assisting producers and processors in meeting regulatory standards.
Nutritional Value and Market Scope
Milk, cheese, yogurt, butter, and ice cream are all dairy products that are a staple in many people's diets because they contain important nutrients like protein, calcium, and vitamins. The dairy industry is a market worth many billions of dollars that is constantly changing to meet the various needs of consumers. However, dairy is highly perishable and susceptible to microbial contamination due to its high nutrient content.
Risks of Microbial Contamination
Microbial contamination can lead to spoilage, reduced shelf life, and costly recalls. More importantly, pathogenic bacteria in dairy products have the potential to transmit food-borne illnesses that range from mild discomfort to severe, potentially fatal conditions. Historical outbreaks involving Salmonella, Listeria monocytogenes, E. coli O157:H7, and Campylobacter highlight the importance of rigorous microbial control.
Sources of Contamination
From the cow's udder and milking equipment to processing surfaces and human handlers, contamination can occur at multiple points along the production chain. Post-processing contamination is especially concerning, as it can bypass pasteurization safeguards.
Objectives of Microbial Testing
Microbial testing in dairy serves several key purposes:
Evolution of Testing Methods
Reliable but slow, traditional culture-based methods frequently take days to produce results. Rapid technologies like immunoassays, PCR, biosensors, and automated systems have emerged to meet the needs of the industry. Pathogens and hygiene indicators can be detected more quickly and accurately with these.
Spoilage Microorganisms
Spoilage microbes degrade product quality without causing disease. Key groups include:
Pathogenic Microorganisms
Pathogens pose serious health risks even in small numbers:
2. Aim:
To highlight the significance of the various methods, indicators, and standards used in dairy product microbial quality testing in ensuring product safety, quality, and public health.
3. Objectives:
4. Sampling Strategies and Sample Preparation
Importance of Sampling in Microbial Testing
Accurate microbial testing begins with robust sampling strategies. A statistically sound sampling plan ensures that collected samples truly represent the batch or production environment. For raw milk, samples are typically drawn from bulk tanks or tanker trucks using aseptic techniques to prevent contamination. Before collection, it is essential to mix thoroughly. To check the integrity of the process, in-process samples are taken at critical control points (CCPs) like the filling, filtration, and pre- and post-pasteurization stages. Using two-class or three-class attribute plans based on risk levels and target organisms, finished product sampling involves selecting packaged items at random. Equally important is sampling the environment. To assess sanitation and find persistent pathogens like Listeria monocytogenes, swabs, sponges, and rinse samples are taken from food-contact surfaces like tanks, pipes, conveyors, and non-contact areas like floors and drains. To ensure the safety of microorganisms, water samples used for cleaning or chilling must also be tested.
Sample Preparation Techniques
Effective sample preparation ensures accurate microbial detection. Homogenization of solid or semi-solid samples (e.g., cheese, yogurt) in sterile diluents like peptone water or saline helps evenly disperse microbes. Care must be taken when using tools like the Stomacher and Waring Blender to avoid contamination and heat. Serial dilutions minimize interference and bring the microbial load down to levels that can be counted. For pathogen detection, enrichment steps—using non-selective and selective broths—enhance sensitivity by promoting target growth while suppressing background flora.
DNA/RNA extraction is essential for molecular techniques like PCR and NGS. In order to get rid of inhibitors like fats and proteins, this involves cell lysis and purification. This is made easier by commercial kits, which guarantee high-quality nucleic acid recovery from complex dairy matrices.
Traditional Culture-Based Methods in Dairy Microbiology
Microbial quality testing in dairy has long relied on traditional microbiological methods, such as plate counts. Despite the rise of rapid techniques, these methods remain widely accepted due to their reliability, affordability, and regulatory approval. In order to estimate the microbial load and identify specific organisms, they involve cultivating microorganisms on agar media under controlled conditions.
Total Plate Count (TPC) / Standard Plate Count (SPC)
The total number of viable aerobic and facultative anaerobic bacteria in a sample is measured by TPC or SPC. It serves as a general indicator of hygiene and microbial load. While elevated counts in pasteurized products point to contamination from post-processing, high counts in raw milk indicate poor storage or hygiene during milking.
Procedure: On Plate Count Agar, samples are homogenized, serially diluted, and plated using pour or spread methods. Incubation occurs at 30–32°C for 48–72 hours. The results are shown in CFU/g or CFU/mL.
Coliform and E. coli Counts
Coliforms are lactose-fermenting Gram-negative rods used as indicators of hygiene and contamination. Fecal coliforms, including E. coli, signal recent fecal contamination.
Procedure: Samples are plated on selective media like VRBA or m-Endo agar and incubated at 35–37°C. For E. coli, MPN methods or chromogenic media (e.g., Chromocult) are used, with confirmatory tests like EC broth or MUG assay
Psychrotrophic Count
Psychrotrophs grow at refrigeration temperatures and are key spoilage organisms in cold-stored milk.
Procedure: Similar to TPC, but incubation is at 7°C for 7–10 days on PCA.
Yeast and Mold Count
Yeasts and Molds spoil dairy products with low water activity or pH, such as cheese and butter.
Procedure: Samples are plated on PDA or MEA, often with antibiotics, and incubated at 25°C for 3–5 days.
Pathogen-Specific Cultural Methods
These methods involve enrichment, selective plating, and biochemical confirmation to detect low levels of pathogens.
6. Rapid Detection Methods
The limitations of traditional culture methods, particularly the long turnaround times, have spurred significant research and development into rapid detection methods. These technologies aim to provide faster, often more sensitive, and sometimes more specific results, enabling quicker release of safe products and more timely intervention in case of contamination. Rapid methods can be broadly categorized into immunological, molecular, and impedimetric/biosensor-based approaches.
A. Immunological Methods
These methods utilize antigen-antibody interactions for specific microbial detection.
ELISA is a plate-based assay commonly used for rapid detection of specific microbial antigens or toxins (e.g., Staphylococcus aureus enterotoxins, Salmonella antigens). It can be performed in various formats (direct, indirect, sandwich, competitive).
Principle: Antibodies specific to the target antigen are immobilized on a solid support (e.g., microtiter plate wells). The sample is added, and if the antigen is present, it binds to the antibodies. A second enzyme-conjugated antibody is then added, which binds to the antigen-antibody complex. A substrate is added, and the enzyme catalyzes a color change, which is measured spectrophotometrically. The intensity of the color is proportional to the amount of antigen present.
Procedure: Often involves an initial enrichment step (4-24 hours) to increase bacterial numbers.
Advantages: High throughput, relatively rapid (hours after enrichment), widely available in commercial kits, good sensitivity and specificity.
Disadvantages: Can be affected by matrix components in dairy products, requires specific antibodies, may still require an enrichment step 23.
LFIAs, also known as dipstick tests or immunochromatographic strips, are simple, rapid, and often qualitative or semi-quantitative tests that can be used for on-site detection.
Principle: The sample migrates along a nitrocellulose membrane by capillary action. If the target antigen is present, it binds to gold-conjugated antibodies in the conjugate pad, forming an antigen-antibody complex. This complex continues to migrate and is captured by a test line containing immobilized antibodies, resulting in a visible colored line. A control line confirms the test's validity 24.
B. Molecular Methods
Molecular methods detect specific nucleic acid sequences (DNA or RNA) of microorganisms, offering high specificity and sensitivity. They have revolutionized pathogen detection in food microbiology .
PCR amplifies specific DNA sequences, allowing for the detection of even very small numbers of target organisms.
Principle: DNA is denatured into single strands, primers bind to specific target sequences, and DNA polymerase synthesizes new DNA strands. This cycle is repeated multiple times (typically 25-40 cycles), leading to exponential amplification of the target DNA.
Types:
Conventional PCR: Detects the presence of amplified DNA fragments by gel electrophoresis, providing a qualitative (presence/absence) result.
Real-time PCR (QPCR): Monitors the amplification process in real-time using fluorescent dyes or probes. This allows for quantification of the initial DNA template and faster results. qPCR is highly sensitive and provides results in a few hours after sample preparation.
Multiplex PCR: Designed to amplify multiple target DNA sequences simultaneously in a single reaction, allowing for detection of several pathogens or different genes from one pathogen.
Reverse Transcription PCR (RT-PCR): Used to detect RNA viruses or mRNA transcripts of bacterial genes by first converting RNA to cDNA using reverse transcriptase, followed by Conventional or real-time PCR.
Procedure: Often requires a DNA extraction step (to remove PCR inhibitors from food matrix) and typically a short (e.g., 6-12 hours) enrichment step to enhance sensitivity25.
LAMP is an isothermal nucleic acid amplification technique, meaning it operates at a constant temperature, eliminating the need for a thermocycler.
Principle:
Uses 4-6 specific primers and a strand-displacing DNA polymerase to amplify DNA with high efficiency. The reaction generates a large amount of DNA, which can be detected visually (e.g., turbidity, color change with pH indicators or fluorescent dyes) .
NGS technologies, particularly metagenomics (sequencing all DNA in a sample), are emerging tools for comprehensive microbial analysis.
Principle: DNA is extracted from a sample, fragmented, ligated with adapters, and sequenced in parallel. The resulting sequence reads are then compared to databases to identify all microorganisms present, including unculturable ones.
C. Impedance/Conductance Methods
These methods monitor changes in electrical impedance or conductance of a growth medium as microorganisms metabolize substrates.
Principle: As bacteria grow in a conductive medium, they metabolize uncharged complex molecules into charged end-products (e.g., amino acids to organic acids). This change in charge alters the electrical impedance or conductance of the medium, which can be detected by electrodes. The time taken for a significant change to occur (detection time) is inversely proportional to the initial microbial concentration .
D. ATP Bioluminescence
ATP bioluminescence measures the amount of adenosine triphosphate (ATP), the universal energy molecule present in all living cells.
Principle: The enzyme luciferase, extracted from fireflies, catalyzes a reaction with ATP, leading to the emission of light. The intensity of the light is directly proportional to the amount of ATP present.
Procedure: Swab a surface or take a liquid sample, extract ATP, add luciferase reagent, and measure light output with a luminometer .
E. Flow Cytometry
Flow cytometry rapidly abelled individual cells or particles in a liquid suspension based on their light scattering and fluorescent properties.
Principle: Cells abelled with fluorescent stains (e.g., DNA stains, viability stains) pass one by one through a laser beam. Detectors measure scattered light and emitted fluorescence, providing information on cell size, granularity, and viability26.
Table 3: Comparison of Rapid Detection Methods
|
Method |
Principle |
Target Microorganisms |
Key Advantages |
Key Disadvantages |
Typical Results Time |
|
ELISA |
Antigen-antibody reaction |
Specific pathogens, toxins |
High throughput, good sensitivity |
Requires enrichment, matrix effects |
Hours (after enrichment) |
|
Lateral Flow Immunochromatography |
Capillary migration of antigen-antibody |
Specific pathogens, toxins |
Very rapid, simple, no equipment |
Lower sensitivity, qualitative |
Minutes |
|
PCR (Qpcr) |
DNA amplification, real-time detection |
Specific pathogens |
High specificity, high sensitivity, rapid |
High cost, skilled staff, inhibitors |
2-4 hours (after extraction) |
|
LAMP |
Isothermal DNA amplification |
Specific pathogens |
Rapid, no thermocycler, visual read |
Primer design complex, potential non-specific |
30-60 minutes |
|
Impedance/Conductance |
Change in electrical properties by metabolism |
General microbial growth |
Automated, reduced labor |
Non-specific, matrix effects |
Hours-1 day |
|
ATP Bioluminescence |
ATP-luciferase light emission |
Total living cells, hygiene |
Extremely rapid, on-site |
Non-specific, sensitive to non-microbial ATP |
Seconds-minutes |
|
Flow Cytometry |
Laser analysis of stained cells |
Total viable count, specific groups |
Very rapid, high throughput, viability |
High cost, complex, skilled operators |
Minutes |
7. Regulatory Frameworks and Standards
Microbial quality testing in dairy products is governed by a complex web of national and international regulations, guidelines, and industry standards. These frameworks aim to ensure consumer safety, promote fair trade, and standardize testing methodologies.
A. International Standards and Guidelines
B. National Regulations
Different countries have their own specific regulations and microbiological criteria for dairy products.
i)United States:
Pasteurized Milk Ordinance (PMO): Developed by the U.S. Public Health Service/FDA, the PMO is widely adopted by states and governs the production, processing, and packaging of Grade "A" milk and milk products. It sets microbial standards for raw milk (e.g., <100,000 CFU/mL individual producer sample, <300,000 CFU/mL commingled milk) and pasteurized milk (e.g., <20,000 CFU/mL standard plate count, <10 CFU/mL coliform count)6.FDA Regulations: The FDA sets limits for pathogens (e.g., zero tolerance for L. monocytogenes and Salmonella in ready-to-eat dairy products).USDA: Oversees meat, poultry, and egg products, but also has some involvement with dairy components in other foods.
ii) European Union (EU):
Regulation (EC) No 2073/2005: Sets microbiological criteria for foodstuffs, including dairy products. It specifies criteria for process hygiene (e.g., enterobacteriaceae in pasteurized milk) and food safety criteria (e.g., L. monocytogenes, Salmonella, E. coli O157:H7 in various dairy products). These regulations are legally binding for all EU member states.Other Countries: Countries like Canada, Australia, New Zealand, and Japan also have comprehensive regulatory frameworks for dairy safety, often aligning with Codex standards but with country-specific nuances.
iii) Microbiological Criteria
Regulatory frameworks typically include microbiological criteria that specify the maximum acceptable levels of microorganisms in a food product. These criteria can be Process Hygiene Criteria Indicate the acceptable functioning of the production process. Exceeding these limits suggests a failure in hygiene practices or process control and requires corrective actions. Examples include TPC and coliform counts in pasteurized milk47.Food Safety Criteria: Define the acceptability of a product in terms of public health. Exceeding these limits indicates a potential health hazard, and the product is considered unsafe or unfit for consumption. Examples include the absence of L. monocytogenes or Salmonella in specific ready-to-eat dairy products.
iv)HACCP and FSMA
Hazard Analysis and Critical Control Points (HACCP): A methodical approach to the prevention of biological, chemical, and physical dangers to food during production processes. In dairy, HACCP plans identify CCPs (e.g., pasteurization, sanitation of equipment) where microbial hazards can be controlled. Microbial testing is crucial for verifying the effectiveness of HACCP plans.Food Safety Modernization Act (FSMA) (USA): Shifts the focus of federal regulators from responding to contamination to preventing it. Dairy producers must adhere to these regulatory frameworks and implement robust microbial testing programs in order to ensure product safety, gain market access, and maintain consumer trust. It mandates preventive controls for food facilities, including specific requirements for dairy processing. These standards are regularly updated to reflect developments in scientific knowledge and detection methods.27
8. Quality Control and Assurance in Dairy Processing
In addition to being a legal requirement, microbial quality testing is an essential component of a comprehensive system of quality control (QC) and quality assurance (QA) throughout the dairy supply chain. From farm to fork, every step presents potential microbial hazards that must be managed.
i) Raw Milk Quality at the Farm
The safety and shelf life of finished goods are directly influenced by the quality of raw milk. Herd Health: Mastitis (udder infection) is a major source of microbial contamination (e.g., Staphylococcus aureus, Streptococcus agalactiae). Good animal husbandry practices and regular veterinary examinations are essential. Hygiene in the milking process: In order to reduce the amount of bacteria present in the milk, it is essential to thoroughly clean and sanitize the teats prior to milking, as well as to promptly cool the milk. Farm Bulk Tank Management: Raw milk should be cooled rapidly to ≤4°C within two hours of milking and maintained at this temperature to inhibit the growth of mesophilic bacteria and slow down psychrotrophic growth. Biofilms are prevented from forming in bulk tanks by regularly cleaning and sanitizing them. Testing at Farm Level: Raw milk from individual producers is often tested for TPC, somatic cell count (SCC - indicator of mastitis), and antibiotic residues before acceptance by processors. A high TPC results in payment rejection or reduction28.
ii) Processing Plant Hygiene and Sanitation
The processing environment is a critical area for preventing cross-contamination and pathogen harbourage.
Cleaning-in-Place (CIP) and Cleaning-Out-of-Place (COP): Regular and thorough cleaning and sanitization of all food contact surfaces, pipes, tanks, and equipment are paramount. CIP systems use automated circulation of cleaning and sanitizing solutions.
Environmental Monitoring Programs (EMP): Routine testing of food contact surfaces and environmental areas for indicator organisms (e.g., coliforms, enterobacteriaceae) and specific pathogens (e.g., Listeria monocytogenes) is crucial. Methods like swabbing, sponging, or rinsing are used. Biofilm Control: Biofilms, which are microbial communities encased in an extracellular polymeric substance, can adhere to surfaces, particularly pipes and crevices, making them highly resistant to sanitizers and serving as persistent sources of contamination (such as Listeria). Positive findings prompt extensive cleaning and retesting. Regular cleaning, proper equipment design, and rotating sanitizers are important for biofilm management29.
ii) Thermal Processing (Pasteurization, UHT)
In order to reduce spoilage microorganisms and eliminate vegetative pathogenic bacteria, heat treatment is an essential control point. Pasteurization: A heating process (e.g., 72°C for 15 seconds for High-Temperature Short-Time - HTST) designed to destroy all non-spore-forming pathogens and most spoilage organisms. Post-pasteurization microbial testing (e.g., phosphatase test for effective pasteurization, coliforms for post-pasteurization contamination) is vital.Ultra-High
Temperature (UHT) Processing: Milk undergoes a higher heat treatment, such as 135-150°C for one to five seconds, to become commercially sterile, extending its shelf life without refrigeration until it is opened. In order to avoid recontamination, strictly aseptic packaging is essential. UHT products are subjected to tests for their microbial stability.
iv) Post-Processing Handling and Packaging
Even after effective heat treatment, products can become re-contaminated during cooling, filling, and packaging if hygiene is compromised.
Aseptic Filling: For UHT and extended shelf life (ESL) products, aseptic fillers are used to prevent microbial ingress during packaging.
Packaging Materials: Packaging materials must be sterile or effectively sanitized and impervious to microbial penetration.
Cold Chain Management: Maintaining the cold chain (refrigeration) from the processing plant to the consumer is critical for refrigerated dairy products to prevent the outgrowth of psychrotrophic spoilage organisms and psychrotolerant pathogens like Listeria monocytogenes30.
V) Finished Product Testing
Final product testing is the last line of defense before products reach the market. It confirms that the product meets regulatory standards and internal specifications.Routine Testing: TPC, coliforms, yeast and mold counts are commonly performed.Pathogen Screening: Products with higher risk (e.g., soft cheeses, unpasteurized products, ready-to-eat items) undergo regular screening for specific pathogens (Listeria monocytogenes, Salmonella, STEC).Shelf-Life Studies: Products are tested over their intended shelf life to monitor microbial growth and ensure quality and safety until the "best before" date.
9. CONCLUSION
Microbial quality testing stands as a cornerstone of the modern dairy industry, transcending regulatory compliance to become a vital safeguard for public health and economic stability. While milk's inherent nutritional content is beneficial to human health, it also provides an ideal environment for the growth of microorganisms. This reality necessitates rigorous and continuous microbial control throughout the dairy production chain—from raw milk collection and processing to packaging and distribution—to ensure safety, extend shelf life, and preserve sensory quality.The evolution of microbial quality assurance has transformed dairy microbiology from basic culture-based testing to rapid, molecular-based methodologies. Traditional plate counts remain important for regulatory validation, but modern tools such as ATP bioluminescence, impedance monitoring, and immunoassays provide faster results for high-throughput operations. Molecular diagnostics, especially Polymerase Chain Reaction (PCR) and quantitative PCR (qPCR), have revolutionized pathogen detection, offering unmatched sensitivity and specificity for organisms such as Listeria monocytogenes, Salmonella spp., and Escherichia coli O157:H7. The integration of testing protocols with robust regulatory frameworks and Hazard Analysis and Critical Control Point (HACCP) systems ensures comprehensive control, shifting microbial control from reactive confirmation to proactive prevention. Identifying and monitoring Critical Control Points (CCPs)—such as pasteurization, cooling, and cleaning cycles—allow microbial testing to serve as verification of system efficacy. For traceability and consumer confidence, accurate records and compliance with microbiological limits are essential. Future obstacles include antimicrobial resistance (AMR), minimally processed dairy products, and global supply chains. Future progress lies in advanced analytics, including whole-genome sequencing (WGS) for outbreak tracing, and AI-driven predictive systems that interpret vast data from sensors and laboratory tests. Point-of-care devices that are portable, quick, and cheap will make it even easier to assess risks in real time. This will push the dairy industry toward a smarter, safer, and preventative approach to dairy microbiology.
REFERENCES



Bheemappagari Rajesh*, P. Saisireesha, Dr. M. Suchitra, A Review on Microbial Quality Testing of Dairy Products, Regulatory Framework and Standards, Quality Control and Assurance in Dairy Processing, Int. J. of Pharm. Sci., 2025, Vol 3, Issue 10, 3222-3236 https://doi.org/10.5281/zenodo.17482463
 10.5281/zenodo.17482463
10.5281/zenodo.17482463